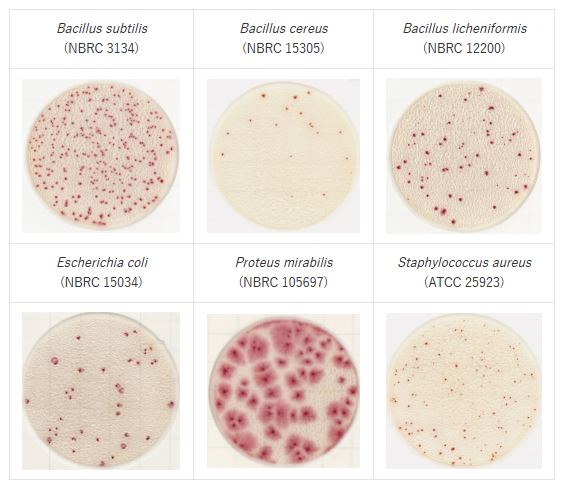
Strains in easy plate AC
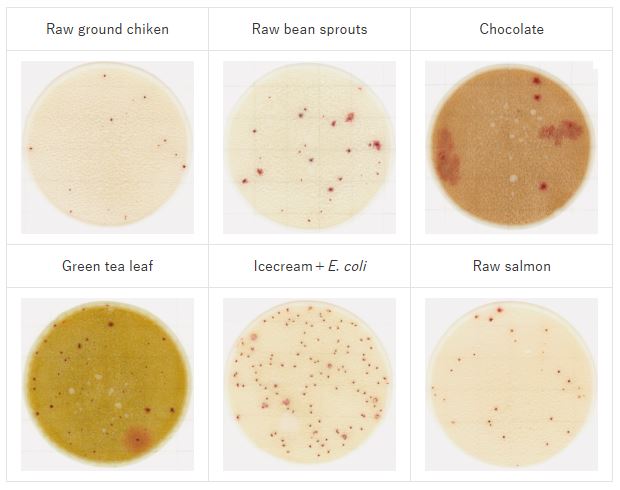
Foods in Easy plate AC

Film medium for general viable bacterial count | Easy Plate AC Kikkoman
1. Introduction to Easy Plate Culture Media
- Easy Plate is a convenient ready-to-use culture medium plate that requires no preparation or sterilization. It is an easy-to-use alternative to preparing media at the laboratory using traditional agar plates, helping to save time, effort, and reduce waste.
- Easy Plate AC is a colony-counting plate developed by Kikkoman Biochemifa (Japan), designed for the enumeration of aerobic bacteria (Aerobic Count) in food, beverages, cosmetics, and various environmental samples.
- Using Easy Plate as a microbiological test kit – with only about 1/20 of the volume of a conventional Petri dish – saves incubator space and allows more tests to be performed simultaneously. Easy Plate is pre-packaged, and once the package is opened, the sample suspension can be applied directly onto the medium and incubation can begin.
- The plate is designed as a dry medium sheet fixed inside a plastic plate, ready to use without the need for media preparation or sterilization.
2. Specifications Easy Plate AC
- Product name: Easy Plate AC
- Product code: 61973
- Application: Enumeration of total aerobic bacteria
- Incubation time: 48 ± 2 hours
- Incubation temperature: 35 ± 1℃
- Storage condition (unopened): 2 – 8℃
- After opening: After opening the package, fold the edge at least twice, seal tightly, store in a refrigerator (2–8℃), and use within 3 months.
- Shelf life: 18 months from the manufacturing date
- Certifications: AOAC RI PTM, MicroVal, NordVal
3. Principle
The Easy Plate AC contains pre-dried culture medium and chromogenic indicator. When 1 mL of sample or diluted sample is applied to the plate surface:
- The sample spreads evenly and dissolves the medium.
- Aerobic bacteria grow and form colonies with characteristic color, making them easy to observe and count.
- Results are read after 48 hours of incubation at the appropriate temperature (35–37℃).
4. Benefits
- Convenient & rapid: No media preparation, no sterilization of equipment, saving time in the laboratory.
- High accuracy: Provides results comparable to the standard Plate Count Agar (PCA) method.
- Easy to use: Compact design, simple handling, suitable for small laboratories or on-site testing.
- Safe & clean: Minimizes direct handling of culture media and reduces risk of cross-contamination.
- Space & cost-saving: Each box contains 100 plates, occupying less storage space compared to conventional agar plates.
- Clear colony visualization: Colonies turn red, making them easier to count, even with food debris or colored samples.
- Proven correlation: High correlation with traditional plate count methods across various food matrices.

5. Applications
Easy Plate AC from Kikkoman is widely applied in microbiological testing across industries:
- Food industry: Enumeration of aerobic bacteria in meat, fish, processed foods, dairy products, confectionery, fruits, vegetables, and seafood.
- Beverage & drinking water industry: Detection of bacteria in purified water, mineral water, bottled water.
- Cosmetics & pharmaceuticals: Evaluation of microbial contamination in products and raw materials.
- Environmental hygiene testing: Assessment of air quality, production surfaces, and processing equipment in factories.
- QC/QA laboratories: Routine quality control testing in production and processing facilities.
6. Result Interpretation
A. Count any colonies that spread as single colony, counting by the central dark area of the colony.
* Do not count thin, microscopic colonies scattered across an area where a colony is spread out.
B. Where multiple colonies are present, count the central dark area of the colony as a single colony. In example B, there are 4 dark area of the colony. This would be counted 4 colonies.

7. Examples
Strains
Foods
- Incubation conditions: 35℃, 48 hours (Diluent: phosphate buffered saline)
- These colorings are for example only.
Pacific Science Technology Euquipment Co.,LTD is the official distributor of Kikkoman products in Vietnam. For quotations and detailed product information, please contact us.






